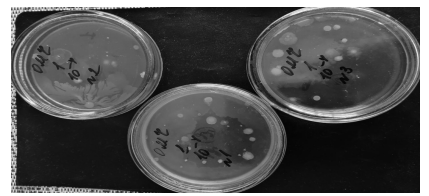

Актуальность темы
Микроорганизмы являются природными биокатализаторами, способными к автоматическому отбору и адаптации для очистки сточных вод с любым содержанием органических загрязнителей [1, 2, 10, 12].
Микробиологическое разрушение широкого ряда полиуглеродистых органических соединений возникает из-за формирования микробной последовательности [8, 9]. Последовательность заключается в том, что конечные продукты (экзометаболиты) «первичных» микроорганизмов-деструкторов являются первичными субстратами для «вторичных» микроорганизмов-деструкторов.
Классическая модель сукцессии была разработана Г. О. Заварзиным для метаногенных микробных сообществ. Согласно этой модели, на первом этапе аэробные, факультативно-анаэробные и «первичные» анаэробные гидролитические микроорганизмы (например, Clostridium) разлагают сложные полимерные соединения (белки, целлюлозу и т. д.) до спиртов и жирных кислот. На второй стадии «вторичные» анаэробы разлагают спирты и кислоты до СН4, СО2 и Н2О. Следует подчеркнуть, что этот тип преемственности происходит последовательно, на каждом этапе по очереди. Так, определенное количество органического вещества поступает в очистную установку или культиватор, где микроорганизмы последовательно разлагают его на конечные продукты. В проточных системах, напротив, органические соединения вводятся непрерывно [4, 11].
Согласно нашей концепции, в проточных системах микроорганизмы, которые выполняют последовательное разрушение органического вещества, могут быть размещены в центре одной из карт пруда-фильтрации. В этом случае изменение физиологических групп в микробном сообществе происходит не во времени, а в пространстве. Следовательно, по нашему определению, этот тип преемственности является «пространственным».
Предлагаемая концепция пространственной последовательности для обработки сточных вод, содержащих широкий спектр органических веществ в высокой концентрации, изложена следующим образом:
1. В проточной системе микробная последовательность определяется не во времени, а в пространстве.
2. При сверхвысоких концентрациях органических веществ (10 000–50 000 мг/л) их разрушение начинается анаэробными микроорганизмами.
3. В анаэробных условиях концентрация органического вещества снижается в 10–100 раз.
4. После деконцентрации органического вещества возникают условия для развития аэробных и факультативно-анаэробных микроорганизмов. Далее основная обработка завершается в системе аэробного потока.
5. Для осуществления пространственной последовательности, обеспечивающей очистку сточных вод от органических веществ, необходимо использование инертных носителей для иммобилизации групп микроорганизмов.
6. После снижения содержания растворенного органического вещества до следовых концентраций (1–2 мг/л) происходит переход от микроорганизмов к низшим беспозвоночным (инфузориям и т. д.).
7. Беспозвоночные организмы удаляют избыток микробной биомассы, потребляя ее. Благодаря этому пространственная последовательность в системе потоков очищает сточные воды не только от широкого спектра концентрированных органических веществ, но и от избыточной микробной биомассы.
Цель работы – провести микробиологическую оценку производственных сточных вод фильтрационного пруда молокоперерабатывающего предприятия при использовании биологической системы очистки.
Материал и методика исследований
Объектом исследований являлись карты фильтрационного пруда сельскохозяйственного предприятия, осуществляющего переработку молока и производства молочной продукции, предназначенные для очистки сточных вод предприятия пищевой промышленности. Суть биологической системы очистки заключалась во введении в сточные воды по индивидуально разработанной технологии микробиологических препаратов. При этом дополнительно осуществлялось нагнетание воздуха в толщу воды специально установленным аэратором на середине первой карты фильтрационного пруда по запатентованной технологии [3].
Отбор проб сточных вод осуществлялся в соответствии с общими требованиями для поверхностных вод ГОСТ 31861-2012. Подготовку проб и проведение исследований осуществляли с использованием стандартных методик. Микробиологические исследования проводили по следующим показателям: колифаги, термотолерантные колиформные бактерии (ТКБ), общие колиформные бактерии (ОКБ), патогенные энтеробактерии родов (Salmonella и Shigella), общее микробное число (ОМЧ), грибы. Санитарно-микробиологическую оценку сточных вод проводили с учетом методических указаний по организации Госсанэпиднадзора за обеззараживанием сточных вод МУ2.1.5.800-99.
Оценка уровня загрязнения проводилась с учетом значений предельно допустимых концентраций (ПДК) химических веществ в воде питьевой систем централизованного, в т. ч. горячего, и нецентрализованного водоснабжения; воде подземных и поверхностных водных объектов хозяйственно-питьевого и культурно-бытового водопользования; воде плавательных бассейнов, аквапарков СанПиН 1.2.3685-21 «Гигиенические нормативы и требования к обеспечению безопасности и (или) безвредности для человека факторов среды обитания» от 28.01.2021 г. № 2.
Результаты исследований и их обсуждение
Отрицательные значения окислительно-восстановительного потенциала означают доминирование анаэробных процессов разрушения растворенного органического вещества. Действительно, при высоких концентрациях органического вещества и при дефиците кислорода микроорганизмы снижают окислительно-восстановительный потенциал до отрицательных значений. С другой стороны, снижение концентрации органического вещества подразумевает высокий (положительный) окислительно-восстановительный потенциал среды в результате доминирования высокопотенциального концевого акцептора электронов. Следовательно, повышенное значение окислительно-восстановительного потенциала означает снижение концентрации органических соединений в растворе, что является показателем эффективности обработки.
Поэтому была проведена оценка доочистки сточных вод в сравнении с аналогичным периодом предыдущего года.
Процесс нитрификации ограничен наружной кислородной средой, тогда как денитрификация происходит преимущественно во внутренних бескислородных зонах. Так, согласно расчетным данным, фактическая эффективность очистки во второй контрольной точке (в месте установки аэратора) была положительной в июне по ХПК – 0,6, БПК5 – 0,55, нитраты – 0,79, хлориды – 0,13, калий – 0,52. В 4-й контрольной точке показатели были следующие: ХПК – 0,72, БПК5 – 0,59, натрий – 0,12, хлориды – 0,27, сульфаты – 0,31, калий – 0.42. В октябре во 2-й и 4-й контрольных точках эффективность очистки была положительной по содержанию фосфатов 0,98 и 0,97, сульфатов – 0,28 и 0,66, калию – 0,05 и 0,07 соответственно. Наблюдалась также изменчивость значений pH и концентрации органических соединений. Параметр pH постепенно снижался с 7,36 до 6,9 во 2-й контрольной точке и с 7,37 до 6,8 – в 4-й контрольной точке.
Для протекания первой фазы нитрификации необходим диапазон температур 25–30°С, который достигается в наших климатических условиях в летний период, при этом аммиак окисляется до азотистой кислоты NH4 + O2 → NO2 + H2O + 2H, NO2 + O2 → NO3. Продуктом жизнедеятельности аммонифицирующих бактерий, род грамотрицательных бактерий (Nitrosomonas), относящихся к семейству бетапротеобактерий, является аммиак, который используют для получения энергии, а их продукты жизнедеятельности (нитриты) служат источником энергии для грамотрицательных и хемоавтотрофных бактерий (Nitrobacter).
За время проведения мониторинга в разрезе по месяцам года наблюдались колебания показателей как в большую, так и в меньшую сторону, что связано с постоянным дополнительным сбросом сточных вод неисследованного и постоянно меняющегося состава.
В зимний период, как правило, возрастает риск микробного загрязнения водоемов у мест водозаборов из-за снижения их самоочищающей способности. Следствием этого является более длительная выживаемость и сохранение вирулентных свойств патогенных микроорганизмов в холодной воде.
В соответствии с санитарными правилами по охране поверхностных вод от загрязнения, сточные воды, опасные в эпидемическом отношении, должны подвергаться обеззараживанию. Обязательному обеззараживанию подвергаются сточные воды при сбросе в водоемы рекреационного и спортивного назначения, при их повторном промышленном использовании и т. д.
Дополнительные лабораторные (микробиологические) исследования показали, что «Вода сточная неочищенная» в объеме проведенных испытаний соответствовала требованиям СанПиН 1.2.3685-21 «Гигиенические нормативы и требования к обеспечению безопасности и (или) безвредности для человека факторов среды обитания» (табл. 1).

Примечание. * «Вода сточная неочищенная» в объеме проведенных испытаний соответствует требованиям СанПиН 1.2.3685-21 «Гигиенические нормативы и требования к обеспечению безопасности и (или) безвредности для человека факторов среды обитания».
Функциональная особенность биопленок зависит от видов микроорганизмов и роли, которую выполняет каждый вид [5–7].
Например, один вид, находясь в глубине биопленки, может осуществлять анаэробную ферментацию, а другой вид на поверхности биопленки реализует аэробный метаболизм. Биопленка формируется из свободно плавающих микроорганизмов, которые прилипают к поверхности посредством вандерваальсовых сил, с последующей более прочной молекулярной и клеточной адгезией. После того как на поверхности создан первоначальный слой, он увеличивается за счет адгезии все большего количества клеток бактерий, грибков, водорослей и простейших. Эти микроорганизмы выделяют значительное количество внеклеточных полимерных веществ, которые прикрепляют их к поверхности, что создает многослойную матрицу.
Микроорганизмы, находящиеся на внешней стороне биопленки, обладают самой высокой скоростью роста, тогда как более медленно растущие бактерии будут находиться внутри. В результате такой организации медленно растущие микроорганизмы будут более защищены от внешних воздействий и от вымывания. Это особенно важно в присутствии ингибиторов. От биопленок могут отделяться сгустки клеток, которые прикрепляются к другим поверхностям и, таким образом, способствуют распространению биопленки.
Признаки образования микробной биопленки в сточной воде наблюдались на 3-и сут после ввода микробиологических препаратов в карту пруда-фильтрации при включенном аэраторе. Нарост был хорошо виден в микроскоп и выглядел как скопление микробных клеток на поверхности носителя (рис. 1).

Рис. 1. Вид пробы сточных вод под микроскопом
На 7-е сут скопления микробной биомассы были хорошо видны невооруженным глазом на поверхности сточных вод, имеющих вид пушистой серой массы. Это повышало мутность сточных вод, но впоследствии происходило их отстаивание и биопленка оседала на дно (рис. 2).

Рис. 2. Скопления микробной биомассы
Анализ исследований биопленки показал, что с понижением температуры она собирается у края обваловки по всему периметру первой карты (частично в месте перелива попадает во вторую карту), уплотняется и оседает на дно. Соответственно собранные в ней жировые взвеси переходят в состав донных отложений, что и затрудняет деструкцию загрязняющих веществ в них.
Для санитарной оценки микробиологической обсемененности применялось определение общего микробного числа (рис. 3). Чем больше объект загрязнен органическими веществами, тем выше ОМЧ.
Рис. 3. Колонии бактерий на мясопептонном агаре
При ферментации субстрата образуются кислые продукты (молочная, уксусная, муравьиная и др. кислоты), которые снижают значение рН и розовый цвет индикатора изменяется на синий, что указывает на положительную реакцию. Образуется газ (Н2 и СО2) – об этом свидетельствовали пузырьки и трещины в толще среды.
Таким образом, при изучении сахаролитических ферментов, выделяемых микробами, учитывали не только явления расщепления тех или иных сахаров по кислотообразованию, но и глубину ферментативного процесса по наличию в питательной среде конечных газообразных продуктов.
Для подтверждения визуальных изменений был введен дополнительный отбор проб биопленки, собирающейся на поверхности воды в карте (табл. 2).

Так, деструкция массовой доли нитратов составила 86 %, подвижного фосфора – 89 %, общего азота – 26 %, хлоридов – 87 %, фосфат-иона – 88 %. Согласно перечисленным теоретическим принципам, вдоль проточной системы аэрации мы наблюдали изменчивость значений pH биопленки и концентрации органических соединений. Параметр pH увеличился с 7,3 до 7,8.
Известно, что сточная вода молокоперерабатывающих предприятий содержит значительное количество белков. Во время разложения белка происходит процесс аммонификации, т. е. расщепление аминогрупп и их накопление в среде в виде NH4 или NH3, эти соединения подщелачивают среду, что и объясняет повышение рН.
Таким образом, подщелачивание биопленки вдоль модуля является показателем снижения концентрации органических веществ и эффективности очистки.
Заключение
На основании приведенных данных можно сделать следующие выводы:
1. Проведенные санитарно-микробиологические исследования сточных вод и биопленки при использовании биологической системы очистки сточных вод молокоперерабатывающего предприятия свидетельствуют о том, что снижение концентрации органического вещества является следствием положительного окислительно-восстановительного потенциала среды.
2 Повышенное значение окислительно-восстановительного потенциала означает снижение концентрации органических соединений в сточной воде, что является показателем эффективности обработки.
КОРОТКО О ВАЖНОМ
ПКЗ «ОМСКИЙ» ПРИСТУПИЛ К СТРОИТЕЛЬСТВУ ЖИВОТНОВОДЧЕСКОГО КОМПЛЕКСА
Строительство животноводческого комплекса на 1,8 тыс. голов крупного рогатого скота началось в Марьяновском районе Омской области, инвестором проекта выступает АО «Племенной конный завод “Омский”» (ПКЗ), сообщает пресс-служба регионального правительства.
«Стартовало строительство молочно-товарной фермы на 1 тыс. 800 голов коров производственной мощностью 16,2 тыс. тонн молока в год», – говорится в сообщении.
Объем собственных и заемных средств предприятия оценивается в 2,1 млрд руб., еще 400 млн руб. – инфраструктурный бюджетный кредит, который оформляет на себя Омская область по федеральной программе для создания объектов транспортной и инженерной инфраструктуры. На эти средства планируется построить водопроводные, электрические сети, подвести газ, а также обновить дорогу к предприятию.
В составе первой очереди, которую планируется завершить к февралю 2024 г., будут возведены доильно-молочный блок, родильное отделение и телятник.
Согласно пресс-релизу, ПКЗ «Омский» – единственное предприятие в Сибири со статусом племенного завода по разведению лошадей, занимается также выращиванием крупного рогатого скота, растениеводством.
На сайте АО «ПКЗ “Омский”» сообщается, что в составе компании функционируют три молочных комплекса, общее количество крупного рогатого скота составляет около 4,4 тыс. голов. Предприятие имеет 3 лицензии, из них 2 лицензии племенного завода по русской рысистой и орловской рысистой породе, и лицензия на племенной репродуктор по русской тяжеловозной породе. Площадь земель сельскохозяйственного назначения – свыше 15 тыс. га.
Источник: https://www.interfax.ru


